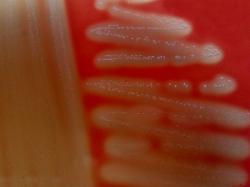

| Streptococcus canis chained cells in BHI broth, Gram staining. |
| Streptococcus septicaemia in Terra Nova dogs - short communication - DVM Costin Stoica |
Necropsy show pleuritis, blood and serum collection
in thorax and pericardum, and spotted skin.
Bacteriological exam has isolated Streptococcus
canis from heart, lungs, liver and bone marrow.
Morphological and biochemical properties:
After 24h incubation at 37 ºC on sheep blood agar,
colonies were 2-3 mm in diameter, white-gray and
beta-hemolytic. No growth on MacConkey agar,
Chapman agar and Bile-esculin agar.
Aerobic, facultatively anaerobic.
API 20 Strep, API 20 A and API 50 CHB strips
(bioMerieux) were used for the biochemical
characterisation. Positive results were obtained for
arginine dihydrolase, alkaline phosphatase and
hippurate hydrolysis.
Acid was produced from fructose, glucose, ribose,
galactose, mannose, cellobiose, maltose, lactose,
N-acetylglucosamine, salicin, saccharose, trehalose
and starch.
Negative results for catalase, alpha- and
beta-galactosidase, beta-glucuronidase, pyrolidonil
arylamydase, oxidase, urease and
Voges-Proskauer test. Acid was not produced from
glycerol, erythritol, D- and L-arabinose, D- and L-
xylose, adonitol, rhamnose, dulcitol, inositol,
mannitol, sorbitol, amygdalin, arbutin, esculin,
inulin, melezitose, raffinose, glycogen, xylitol,
gentibiose, turanose, lyxose, tagatose, D- and
L-fucose, gluconate, 2- and 5-ketogluconate.
Esculin hydrolysis was negative in API 20 Strep and
positive after 48h incubation in API 20 A.
Using "ABIS online" software the strain was
identified as Streptococcus canis 91%.
in thorax and pericardum, and spotted skin.
Bacteriological exam has isolated Streptococcus
canis from heart, lungs, liver and bone marrow.
Morphological and biochemical properties:
After 24h incubation at 37 ºC on sheep blood agar,
colonies were 2-3 mm in diameter, white-gray and
beta-hemolytic. No growth on MacConkey agar,
Chapman agar and Bile-esculin agar.
Aerobic, facultatively anaerobic.
API 20 Strep, API 20 A and API 50 CHB strips
(bioMerieux) were used for the biochemical
characterisation. Positive results were obtained for
arginine dihydrolase, alkaline phosphatase and
hippurate hydrolysis.
Acid was produced from fructose, glucose, ribose,
galactose, mannose, cellobiose, maltose, lactose,
N-acetylglucosamine, salicin, saccharose, trehalose
and starch.
Negative results for catalase, alpha- and
beta-galactosidase, beta-glucuronidase, pyrolidonil
arylamydase, oxidase, urease and
Voges-Proskauer test. Acid was not produced from
glycerol, erythritol, D- and L-arabinose, D- and L-
xylose, adonitol, rhamnose, dulcitol, inositol,
mannitol, sorbitol, amygdalin, arbutin, esculin,
inulin, melezitose, raffinose, glycogen, xylitol,
gentibiose, turanose, lyxose, tagatose, D- and
L-fucose, gluconate, 2- and 5-ketogluconate.
Esculin hydrolysis was negative in API 20 Strep and
positive after 48h incubation in API 20 A.
Using "ABIS online" software the strain was
identified as Streptococcus canis 91%.
| Antibiogram |
| Encyclopedia |
| Culture media |
| Biochemical tests |
| Stainings |
| Images |
| Movies |
| Articles |
| Identification |
| Software |
(c) Costin Stoica
| R E G N U M PROKARYOTAE |
| Back |
| Serous pleuritis, clear red-pink fluid collection |
| Beta-hemolytic colonies on Sheep Blood Agar. |
Streptococcus canis is a pathogenic bacteria that can produce in dogs and cats dermatitis,
pharyngitis, sinusitis, septicaemia, otitis, vaginitis and metritis. In bovines may produce
mammitis. It is rarely isolated from humans, but may be involved in septicaemic infections.
In this case all, puppies from three females belonging to the same breeder, died after 1 to 4
days from birth. The laboratory received a recently died, 4-days-old, puppy.
pharyngitis, sinusitis, septicaemia, otitis, vaginitis and metritis. In bovines may produce
mammitis. It is rarely isolated from humans, but may be involved in septicaemic infections.
In this case all, puppies from three females belonging to the same breeder, died after 1 to 4
days from birth. The laboratory received a recently died, 4-days-old, puppy.
Lancefield grouping was determined by latex agglutination (Streptococcal Grouping Kit, Oxoid).
The strain reacted with Lancefield Group G antisera.
Antibiogram results: sensible to Gentamicin, Florfenicol, Fosfomycin, Doxycycline, Amoxicillin,
Ampicillin, Lincomycin, Furazolidone, Enrofloxacine, Erithromycin; resistant to Neomycin,
Sulphamethoxazole+Trimethoprim and Oxitetracycline.
The strain reacted with Lancefield Group G antisera.
Antibiogram results: sensible to Gentamicin, Florfenicol, Fosfomycin, Doxycycline, Amoxicillin,
Ampicillin, Lincomycin, Furazolidone, Enrofloxacine, Erithromycin; resistant to Neomycin,
Sulphamethoxazole+Trimethoprim and Oxitetracycline.